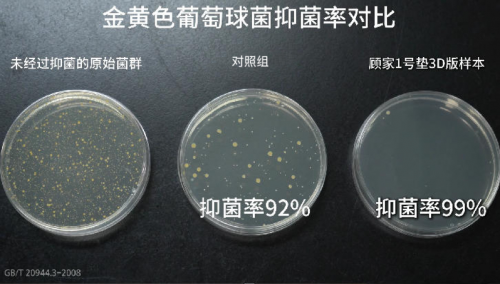

近期,顾家家居在杭州成功举办以“WO心赢未来 乘SHI谋新篇”为主题的卧室经销商大会,期间顾家床垫重磅发布3D新技术,拉开顾家床垫3D升级普及风暴的序幕。

随着生活节奏加快,入睡困难、睡眠浅、早醒、打鼾等睡眠问题,逐渐成为威胁现代人身心健康的首要因素。中国睡眠研究会发布的《2024中国居民睡眠健康白皮书》显示,当下国内有超过3亿人存在睡眠障碍,其中成年人失眠率高达38.2%。而睡眠问题无疑会进一步引发免疫力下降、心血管疾病风险、情绪问题、加速衰老等健康隐患,其对人身健康的危害不容忽视。
针对现代人普遍面临的睡眠问题,顾家床垫在此次经销商大会提供针对性解决方案:其特别推出的全新升级的3D床垫,通过搭载新一代3D技术,在抑菌除螨、抗干扰性、透气散热、支撑性等领域表现卓越,生动阐释科技赋能健康睡眠的实现路径。
何为3D床垫?
顾家3D床垫始于2016年,至今已是顾家3D床垫诞生的10周年。
顾家家居床垫事业部产品研发洞察与设计部负责人张雅芝在会上介绍,顾家家居在2015年便开始调研,针对市场对床垫透气性、支撑性、防螨的迫切需求,顾家于2016年正式发布第一代3D床垫——1号垫3D版,一经上市便备受瞩目。到底什么是3D床垫,相比普通床垫其性能有何不同?大会期间顾家家居的合作研发伙伴德国穆勒公司全球研发总监Sarah对相应技术做出详细阐释。

3D的定义已广为人知,即空间中具有长、宽、高三个维度的立体形态和技术,而穆勒3D是指两面复丝加中单支撑单丝,由经编机器一体纺织成型的三维针织网布。3D材质具有高透气性、高减震性、理想的压力分布、温度调节等多重优势,应用于床垫可使其具有普通床垫所不具备的前述性能。
新3D技术再创新突破
值得一提的是,德国穆勒集团处于工艺纺织品长期市场领导者地位,是全球唯一专业生产三维针织网布的生产企业。此次大会隆重介绍了穆勒与顾家家居联合开发的新3D技术——石墨烯抑菌防螨3D,意味着3D技术将被重新定义。经历十年创新发展,顾家家居对“什么是3D床垫”做出了新的诠释。
大会围绕三大核心功能,介绍了新3D技术作出的突破。在透气和散热功能方面,透气性测试得出的数值越大表示通气性越好。对比三种材质的表现,海绵的透气量为68.28 l/dm²/min,普通3D透气量为海绵的30倍,而石墨烯抑菌防螨3D的透气量是普通3D的1.68倍。

抑菌防螨方面,顾家与穆勒共同研发的抗菌及石墨烯产品可达到更高的抗菌率,其中,抵抗大肠杆菌的抗菌率达91%,抵抗金黄色葡萄球菌ATCC 6538达99%,相比国家标准值的70%分别高出了21%和29%;螨虫趋避率达74.56%,显著高于国家标准的60%。
对于支撑性,石墨烯3D材质每平方厘米有77个支撑点,单片超227万个支撑点,通过精准的压力分布,能够精准贴合人体曲线实现分区承托,有效分散人体重量,减少局部压力集中的现象。
三大优势守护一夜好眠
相比弹簧、椰棕、海绵等普通床垫支撑点较少、热量和湿气易积聚以及易滋生螨虫等短板问题,顾家家居的3D床垫在抑菌防螨、支撑性强、透气散热三大核心功能上有显著优势,能够科学地为使用者提供优质的睡眠环境,从而有效缓解睡眠问题。
针对三大核心优势,顾家家居在此次大会介绍了公司此前所做的对比测评实验。在抑菌除螨效果方面,测试时分别在顾家1号垫3D版和其他品牌床垫上截取了相同大小材质的样本,送往具有专业资质的第三方实验室依据国家标准进行严格测试。
测试结果显示,对照组产品样本的螨虫趋避率仅为53.89%,不具备防螨效果。而顾家1号垫3D版样本则为78.21%,远超60%的国家标准;抑菌效果上,对照组产品样本对于金黄色葡萄球菌和大肠杆菌的抑菌率分别为92%和80%,顾家1号垫3D版样本对两种细菌的抑菌率均为99%。测试结果表明顾家床垫的抑菌防螨率远远超过国标。
抗干扰性方面,测试主要通过放5公斤哑铃、坐下、起跳和搭积木4项测试对3款床垫进行测评。其中,具有显著差异的是起跳测试,测评过程中分别在3个床垫的一侧放置玻璃鱼缸,另一侧由测评者在相同位置以相同力度起跳,观察发现顾家床垫的水位变化小,其他产品的水位波动幅度大。

上述优势主要得益于德国穆勒3D材质为床垫提供的减震效果,让顾家床垫可有效避免因多位使用者相互干扰而破坏睡眠的情况。

透气散热方面,测评使用了密封道具模拟人体躺压后的空气流动情况,气压计的读数可直观反映床垫透气性,气压变化越接近环境大气压说明床垫越透气。测试当天环境大气压为101kPa,测试结果显示顾家1号垫3D版床垫的数值高达100.23kPa。

在散热性对比实验中,顾家家居委托第三方实验室进行实验,在恒温恒湿的空间里放置身上带有传感器的暖体假人模拟睡眠状态,观察90分钟之内假人身体各部位的皮肤温度变化。最终结果显示,顾家床垫的表面温度始终保持在33.8℃,具有更强的散热性。

上述测评实验直观呈现了顾家3D新技术床垫,在抑菌防螨、透气散热、支撑性(抗干扰性)方面具备的显著优势,这将掀起3D床垫升级普及风暴,打开健康睡眠革命新篇章。
以科技赋能深睡
值得一提的是,顾家家居是中国首家通过德国IGR认证的床垫品牌。

IGR人体工程学认证具有极高的权威性与专业性,始创于1998年的德国纽伦堡,具有26年专业经验,500+认证产品和300+认证合作伙伴。
IGR亚太区首席代表许辉在大会上介绍,人体工学是一种以人为本的设计哲学,其核心在于使我们所处的环境与使用的工具,完美适配于人的自然生理结构与行为习惯。
在许辉看来,所有日常器具中,床垫是我们与之接触时间最长,且身体处于最无防备状态的关键物品之一,一张优秀的人体工学床垫,本质上是一场关于夜间健康修复的科学工程。约60%的受试者在使用符合人体工学标准的床垫后,背痛症状减轻或完全消失;75%的长期使用者表示有效减少了肢体麻木与压迫感。人体工学床垫还能显著提升入睡效率并改善睡眠质量。

作为首家通过德国IGR认证的床垫品牌,顾家家居正是通过科技赋能的方式,孜孜不倦地追求着新的突破,以期有效解决消费者面临的普遍睡眠困扰。
此次大会,顾家家居郑州经销商陈靖南分享了3D床垫的销售经验。通过郑州816业绩达成情况来看,3D床垫的高增长带动了床垫和卧室的增长,卧室和床垫的同比增长率分别为116%和144%,而3D床垫的同比增长率则高达909%。由此可见3D床垫在市场的受欢迎程度之高。

此次顾家家居重磅发布搭载穆勒新技术的3D系列床垫,不仅是对3D床垫的重新定义,更是开启了床垫3D升级普及风暴。其通过高性能与睡眠科技的再一次突破,实现了全行业领先的产品质价比,让市场直观感受到最新3D技术为床垫行业注入的全新变革与想象空间,以技术创新实力持续引领行业发展。
 【广告】免责声明:本内容为广告,不代表蚌埠新闻网的观点及立场。所涉文、图、音视频等资料之一切权力和法律责任归材料提供方所有和承担。蚌埠新闻网登载此文出于传递更多信息之目的,对此文字、图片等所有信息的真实性不作任何保证或承诺。文章内容仅供参考,不构成投资、消费建议。据此操作,风险自担!!!
【广告】免责声明:本内容为广告,不代表蚌埠新闻网的观点及立场。所涉文、图、音视频等资料之一切权力和法律责任归材料提供方所有和承担。蚌埠新闻网登载此文出于传递更多信息之目的,对此文字、图片等所有信息的真实性不作任何保证或承诺。文章内容仅供参考,不构成投资、消费建议。据此操作,风险自担!!!










